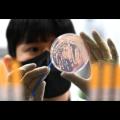

지난 뉴스

수원시, 광교서 '양자 바이오서밋' 국제회의 연다
경기도, 성균관대학교 양자생명물리과학원, 아주대학교 과학기술정책대학원, 가톨릭대학교 성빈센트병원, 아주대의료원, 관련 기업·협회 등 총 12개 양자·바이오 관련 기관·기업과 컨소시엄을 구성해 행사를 진행한다. 시 관계자는 "제1회 광교 양자 바이오서밋은 양자 기술을 활용한 첨단 바이오 혁신과...
머니투데이 | 기사작성일 : 2025-07-08

[따뜻한 경영] 청각장애 아동 사회 진출 도와주는 'KT꿈품교실'...3만200...
지난 2019년에는 캄보디아 프놈펜 소재 국립의료원 프리엉동 병원에도 개소했다. 캄보디아 최초 청각장애인을 위한 수술과 원격 진료, 재활치료가... KT는 지난 5월 KT꿈품교실의 난청 아동과 가족 등 22명을 경기 수원시 KT위즈파크로 초청해 '어린이 드림투어' 행사를 개최하기도 했다.
소비자가 만드는 신문 | 기사작성일 : 2025-07-08

방문재활·보건인력 대상 교육 활성화 간담회 개최
경기도의료원 수원병원은 7일 수원시 권선구 호매실장애인종합복지관과 간담회를 갖고, 지역사회 장애인의 건강 증진과 복지 향상을 위한 협력 방안을 논의했다. 이번 간담회는 복지관을 이용 중인 장애인 중에서 거동이 불편하거나 지속적인 재활 치료가 필요한 대상자에게 보다 적극적이고 체계적인 방문재활...
더리포트 | 기사작성일 : 2025-07-07

[창간 34주년] 일상화된 '3폭 시대' 철저한 대비·세심한 관리로 인명·...
50대 군포 시민이 지난달 초 야외활동 중 어지러움 등을 호소해 의료기관에서 열탈진 증상을 받자, 도는 경기 기후보험 온열질환 보장 항목으로 10만... 지난해 11월 1일 수원시청 대강당에서 열린 '우리집 탄소모니터링' 사업 전문홍보단 제1기 지구지키미 발대식 참석자들이 탄소중립과 관련한 팻말을 들고...
중부일보 | 기사작성일 : 2025-07-07
광주 초등학교 집단 식중독 의심 환자 32명으로 증가
지난 5월 19일 경기 수원시 권선구 경기도보건환경연구원에서 연구원이 식중독균 배양분리작업을 하고 있다. /뉴시스 광주 한 초등학교에서 발생한... 이 중 3명은 병원에 입원해 치료를 받고 있는 것으로 전해졌다. A 초등학교는 당분간 급식을 중단하고 대체식을 제공한다. 보건 당국은 종사자와 유증상자...
남도일보 | 기사작성일 : 2025-07-07
[더벨][Company Watch]서한, 요양시설 사업 진출…수도권 존재감 확대
현재 포레스트케어홈즈가 운영 중인 요양원은 총 4곳으로 △수지점(경기 용인시 수지구) △수원점(경기 수원시 팔달구) △파주점(경기도 파주시) △인천점(인천시 서구) 등이다. 전문 의료 서비스와 일상 생활 지원, 재활 프로그램, 문화·취미 등 추가 서비스를 제공하고 있다. 서한은 지난 1분기에...
더벨 | 기사작성일 : 2025-07-07

[창간 34주년] 31개 시·군 단체장 평균 공약 달성률 58.88%
먼저 수원시는 '공공주택 1만 호 건설 추진'·'자원회수시설 이전 추진'·'경기 국제공항 건설 지원' 등이 각각 2028·2032·2035년에 마무리될 것으로... 화성시에선 '화성컨벤션센터 건립 추진'·'시립미술관 건립'·'화성시립 종합의료원 건립'·'봉담 IC 하이패스 전용 톨게이트 설치' 등이 임기 내 마무리가...
중부일보 | 기사작성일 : 2025-07-06

보행 환경별 맞춤 보조… 걷기 안전 ‘성큼성큼’ [김동환의 김기자와 ...
6㎏ 무게 제품 허리 착용하고 걷자 걷기 수월해지고 관절 등 충격 줄어 재활 치료·시니어 헬스케어 활용 기대 걷기가 기본 운동이자 건강을 지키는... 경기 수원시 영통구보건소와 임상연구를 진행했고, 보조 보행 기능이 고령자 보행 능력 개선에 미치는 효과를 확인했다고 논문은 설명했다. 보행 훈련은...
세계일보 | 기사작성일 : 2025-07-05

AI 13시 시보뉴스_안성 경찰, 40대 남성 긴급체포
사업으로, 수원시는 하반기 착공을 목표로 하고 있으며 지식산업센터, 벤처기업, 소프트웨어 시설 등이 입주할 예정입니다. 경기도가 용인시 구갈동에... 고대 안산병원 신경외과는 2014년 집중 치료실을 확보한 이후 지속적으로 수술 건수를 늘려왔으며, 지난해에만 200건 이상의 수술을 진행하는 등 지역 내...
SK브로드밴드 | 기사작성일 : 2025-07-03

[Who Is ?] 최태원 SK그룹 회장 겸 대한상의 회장
1960년 12월3일 경기 수원시에서 최종현 전 선경그룹(현 SK그룹) 회장의 장남으로 태어났다. 서울 신일고등학교를 나와 고려대학교 물리학과를... 특히 사회성과 분야에서는 SK텔레콤이 개발한 보이스피싱 예방서비스로 3575억 원, SK바이오팜의 자체 개발 뇌전증 치료제가 351억 원을 창출했다. SK그룹은...
비즈니스포스트 | 기사작성일 : 2025-07-03

수원시체육회 종목단체장위원회, 수원본바른한방병원과 업무협약
협약은 시체육회 소속 선수들의 경기력 유지와 향상을 목적으로 체결됐습니다. 협약에 따라 시체육회 소속 선수들과 임직원들은 정기적인 검진과 치료 서비스를 제공받게 됩니다. 시체육회 종목단체장위원회는 시체육회 62개 종목단체의 활성화와 수원시 체육발전을 위해 활동하는 단체입니다. 김용 대표원장은...
경인방송 | 기사작성일 : 2025-07-02

[미래를 여는 대학] '인류와 미래사회 위한 담대한 도전'… 성균관대 자...
대학은 수원시와 경기도, 지역 내 기술 기반 기업·기관들과 협력해 '경기지역 과학기술창업 촉진 체계(Regional Science-Tech Acceleration System)'를 구축하고... 세포치료나 유전자치료 등 임상연계 연구를 수행하는 첨단 재생의료 및 병원 부설 연구소 등 다양한 분야로 진출할 수 있다. 성균관대 관계자는 "신약 개발은...
중부일보 | 기사작성일 : 2025-07-02

[픽! 시니어금융]② KB, 퇴직연금 42.7조 적립…13년차 '골든라이프' 위...
올해는 추가로 노인의료복지시설인 경기 수원시 광교빌리지(8월), 강동빌리지(10월)를 순차적으로 개소할 계획이다. 특히 광교빌리지는 KB골든라이프케어의 빌리지 가운데 최대 시설 정원인 180명(1인실 80명, 2인실 100명) 규모로 지어진다. 이외에도 데이커어센터 2곳을 광교와 강동에 건설한다. KB금융...
블로터 | 기사작성일 : 2025-07-02

수원시, 7월 1일부터 병원·장례식장 무인민원발급기 24시간 운영
무인민원발급기를 24시간 운영 체제로 전환하는 기관은 ▲ 아주대학교병원 ▲ 가톨릭대학교 성빈센트병원 ▲ 동수원병원 ▲ 경기도의료원 수원병원 ▲ 화홍병원 ▲ 수원시 연화장 등 6곳이다. 무인민원발급기로 주민등록등본, 가족관계증명서를 비롯해 121종의 민원서류를 발급받을 수 있다. 병원·장례식장에...
더리포트 | 기사작성일 : 2025-07-01
[부고] 류근관(서울대 경제학부 교수)씨 장모상 외
29일, 경기 고양 국민건강보험공단 일산병원 장례식장 8호실, 발인 7월 1일 오전 7시, 장지 자하연 분당. ☎ 031-900-0444 ■ 이상용(울주군청... ☎ 054-433-9444 ■ 류근관(서울대 경제학부 교수)씨 장모상 △ 음금순(향년 95세)씨 별세, 이미정(여성정책연구원 명예선임연구위원)·이미경(전 수원시의회...
뉴시안 | 기사작성일 : 2025-06-30

7월부터 경기도 병원 7곳 '24시간 진료'… 수지접합·분만 등 5개과목 해...
7월부터 경기도를 비롯한 전국 30곳의 2차 병원에서 화상·수지접합·분만·소아청소년·뇌혈관 등 5개 과목의 환자를 24시간 진료한다. 해당 과목은 치료... 이 가운데 경기지역은 ▶수지접합 분야 2곳(부천시 예손병원, 성남시 분당구 국군수도병원) ▶분만 분야 5곳(성남시 분당구 분당제일여성병원, 수원시...
중부일보 | 기사작성일 : 2025-06-30

수원시, 7월부터 병원·장례식장 6곳 무인민원발급기 24시간 운영
시에 따르면 대상 기관은 아주대병원, 가톨릭대 성빈센트병원, 동수원병원, 경기도의료원 수원병원, 화홍병원, 수원시 연화장이다. 이곳의 무인민원발급기를 이용하면 주민등록등본, 가족관계증명서 등 민원서류 121종을 발급받을 수 있다. 시 관계자는 "앞으로 병원과 장례식장에서 시간 제약 없이 편리하게...
뉴스1 | 기사작성일 : 2025-06-30
[부고]김용길 별세 外
◇김용길 씨 별세·광국 프로축구 울산 HD 대표이사 부친상=29일 경기 고양시 국민건강보험공단일산병원, 발인 7월 1일 오전 7시 031-900-0444... 전 수원시의회 의원 모친상·류근관 서울대 경제학부 교수(전 통계청장) 장모상=29일 경기 수원시 아주대병원, 발인 7월 1일 오전 7시 15분 031-219-6654...
동아일보 | 기사작성일 : 2025-06-30

[수원시정 AM] 수원시 행정전화번호 국번, 228에서 5191 전면 변경 등
24시간 운영 체제 전환 기관은 아주대학교병원, 가톨릭대학교 성빈센트병원, 동수원병원, 경기도의료원 수원병원, 화홍병원, 수원시 연화장 등 6개소다. 무인민원발급기로 주민등록등본, 가족관계증명서를 비롯해 121종의 민원서류를 발급받을 수 있다. 병원·장례식장에 설치된 무인민원발급기는 그동안...
경기신문 | 기사작성일 : 2025-06-30

의료법인한성재단 S서울병원, 수원시 영통구 매탄1동에 이웃돕기 성금 30만 원 후원
(한국글로벌뉴스 - 박소연 기자) 지난 27일,의료법인한성재단 S서울병원에서 운영하고 있는 수원시 영통구 매탄동 소재 S서울병원은 척추·관절 전문병원으로 정형외과,...
한국글로벌뉴스 | 기사작성일 : 2025-06-30
상기 뉴스 정보는 지능형 빅데이터분석에 의해 약 99%의 정확도로 제공됩니다.
 1.0℃
1.0℃
